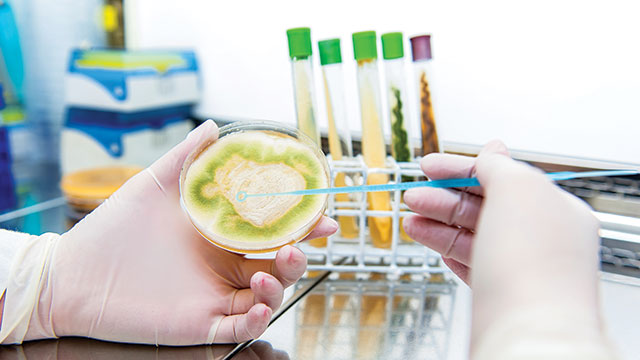

Trichoderma sp. atau Trichoderma adalah sejenis cendawan (fungi) yang tergabung dalam divisi Ascomycetes. Mikroorganisme ini memiliki fungsi antifungal, sehingga bermanfaat sebagai pupuk biologis tanah dan biofungisida.
Ketergantungan industri perkebunan dan pertanian kita terhadap bahan-bahan kimia memang harus berhenti. Hal ini demi menjaga kelestarian alam dan keberlangsungan hidup manusia.
Penggunaan bahan kimia, terutama yang bersifat racun, sangat berbahaya. Dalam waktu lama, dampaknya akan terlihat pada penurunan kualitas tanah dan hasil alam yang kita tanam.
Salah satu langkah yang bisa kita pilih untuk meminimalisir hal tersebut yakni dengan menggunakan trichoderma. Lantas, bagaimana sih cara memanfaatkan jenis jamur ini? Berikut penjabarannya.
Habitat, Pertumbuhan, dan Morfologi Trichoderma
Sebelum mencari tahu bagaimana trichorderma bekerja sebagai pupuk alami, ada baiknya kita mengenal lebih mendalam terkait habitat, reproduksi dan morfologi dari mikroba yang satu ini.
Secara umum, habitat asli trichoderma dapat kita temukan di tanah hutan, tanah pertanian atau substrat berkayu dengan temperatur suhu lingkungan yang berbeda-beda.
Beberapa spesies dapat hidup pada temperatur yang rendah, sedang yang lainnya hanya bisa berkembang biak pada suhu yang cukup tinggi yakni berkisar 37-41 C.
Berbeda dengan yang ada di alam liar, jenis cendawan yang dikultur justru tumbuh secara optimal pada suhu 25-30 C. Mereka mati atau berhenti berbiak jika suhu lebih dari 35 C.
Faktor lain yang memengaruhi pertumbuhan trichoderma adalah kelembapan. Apabila kandungan CO2 meningkat, maka kondisi pH untuk pertumbuhannya akan bergeser menjadi semakin basa.
Menyoal morfologi, identifikasi terhadap mikroba ini dapat kita lihat berdasarkan media pertumbuhannya. Pada media yang kandungan nutrisinya terbatas, bentuk fisik koloni terlihat transparan.
Sedangkan pada media yang nutrisinya lebih banyak, bentuk fisik mereka tampak lebih jelas dengan dominasi warna putih. Sebagai organisme aseksual, jenis fungi ini dapat membentuk spora konidia.
Pertumbuhan konidia sendiri terjadi kurang lebih satu minggu. Warna spora tersebut umumnya terlihat agak kekuningan, hijau atau bahkan keputih-putihan.
Berbeda dengan yang ada di alam liar, jenis cendawan yang dikultur justru tumbuh secara optimal pada suhu 25-30 C. Mereka mati atau berhenti berbiak jika suhu lebih dari 35 C. Foto: Shutterstock.
Fungsi dan Manfaat Trichoderma sebagai Antifungal
Berdasarkan Jurnal Agroteknos keluaran Universitas Halu Oleo, trichoderma adalah salah satu jenis jamur atau fungi yang bisa bermanfaat sebagai biokontrol.
Hal ini sebab karakter antagonis fungi tersebut bagi jamur lainnya, terutama yang bersifat patogen. Aktivitas antagonis ini meliputi parasitisme, predasi atau pembentukkan toksin antibiotis.
Bagi keperluan bioteknologi agen biokontrol ini juga bisa diisolasi dari trichoderma, lalu berguna menangani masalah kerusakan tanaman akibat penyakit atau parasit pada inang.
Menurut pakar, jenis cendawan ini mampu memproduksi metabolit yang bersifat volatil dan non valtil. Kedua senyawa inilah yang mencegah berkembangnya parasit pada pertumbuhan tanaman.
Manfaat trichordema sebagai pupuk biologis dan biofungisida sebenarnya sudah awam ketahui sejak lama. Warga percaya, pupuk ini mampu menjaga pertumbuhan akar dan mencegah risiko pembusukan.
Meski sangat bermanfaat, penggunaan pupuk alami ini terbilang masih jarang di masyarakat. Hal ini dikarenakan oleh hasil pengaplikasiannya yang terhitung lama ketimbang jenis pupuk kimia.

Meski sangat bermanfaat, penggunaan pupuk alami ini terbilang masih jarang di masyarakat. Foto: Shutterstock.
Cara Membuat Pupuk Biologis Tanah dan Biofungisida
Melansir laman resmi Balai Pengkajian Teknologi Pertanian Bali, salah satu cara membuat pupuk alami trichoderma secara mudah adalah dengan “memancing” mereka keluar dari habitat aslinya.
Salah satu lokasi yang paling cocok untuk memanjang fungi ini keluar adalah huta bambu. Caranya dengan memasukkan nasi ke dalam bambu yang sudah terbelah, lalu tanamkan di sekitar area hutan.
Ukuran kedalaman tanam sendiri berkisar 10-20 cm. Kemudian, biarkan selama 5-10 hari sampai jamur tersebut keluar dengan tanda corak bewarna putih, hijau atau biru pada permukaan nasi.
Selain cara di atas, langkah pembuatan pupuk trichoderma juga bisa kita lakukan dengan metode isolasi. Agar tidak salah, berikut tahap-tahap yang bisa Anda aplikasikan:
- Keruk tanah dari area hutan bambu sebanyak 1-2 kg;
- Sipkan Ember atau media lain yang dapat digunakan untuk mengisolasi jamur;
- Masukkan tanah yang sudah disiapkan ke dalam ember sampai sepertiga bagian;
- Kemudian letakkan daun bambu di atas permukaan tanah di dalam ember tersebut;
- Letakkan nasi di atas permukaan daun, lalu tebarkan secara merata;
- Tutup wadah dengan kain, namun jangan terlalu rapat atau kedap udara; dan
- Tunggu 5-15 hari sampai jamur berwarna putih, hijau atau biru keluar.
Taksonomi Trichoderma
Referensi:
Gusnawaty H.S, dkk., Universitas Halu Oleo
Laman Dinas Perkebunan Kalimantan Timur
Laman Universitas Nahdatul Ulama
Balai Pengkajian Teknologi Pertanian Bali
Penulis: Yuhan Al Khairi












































